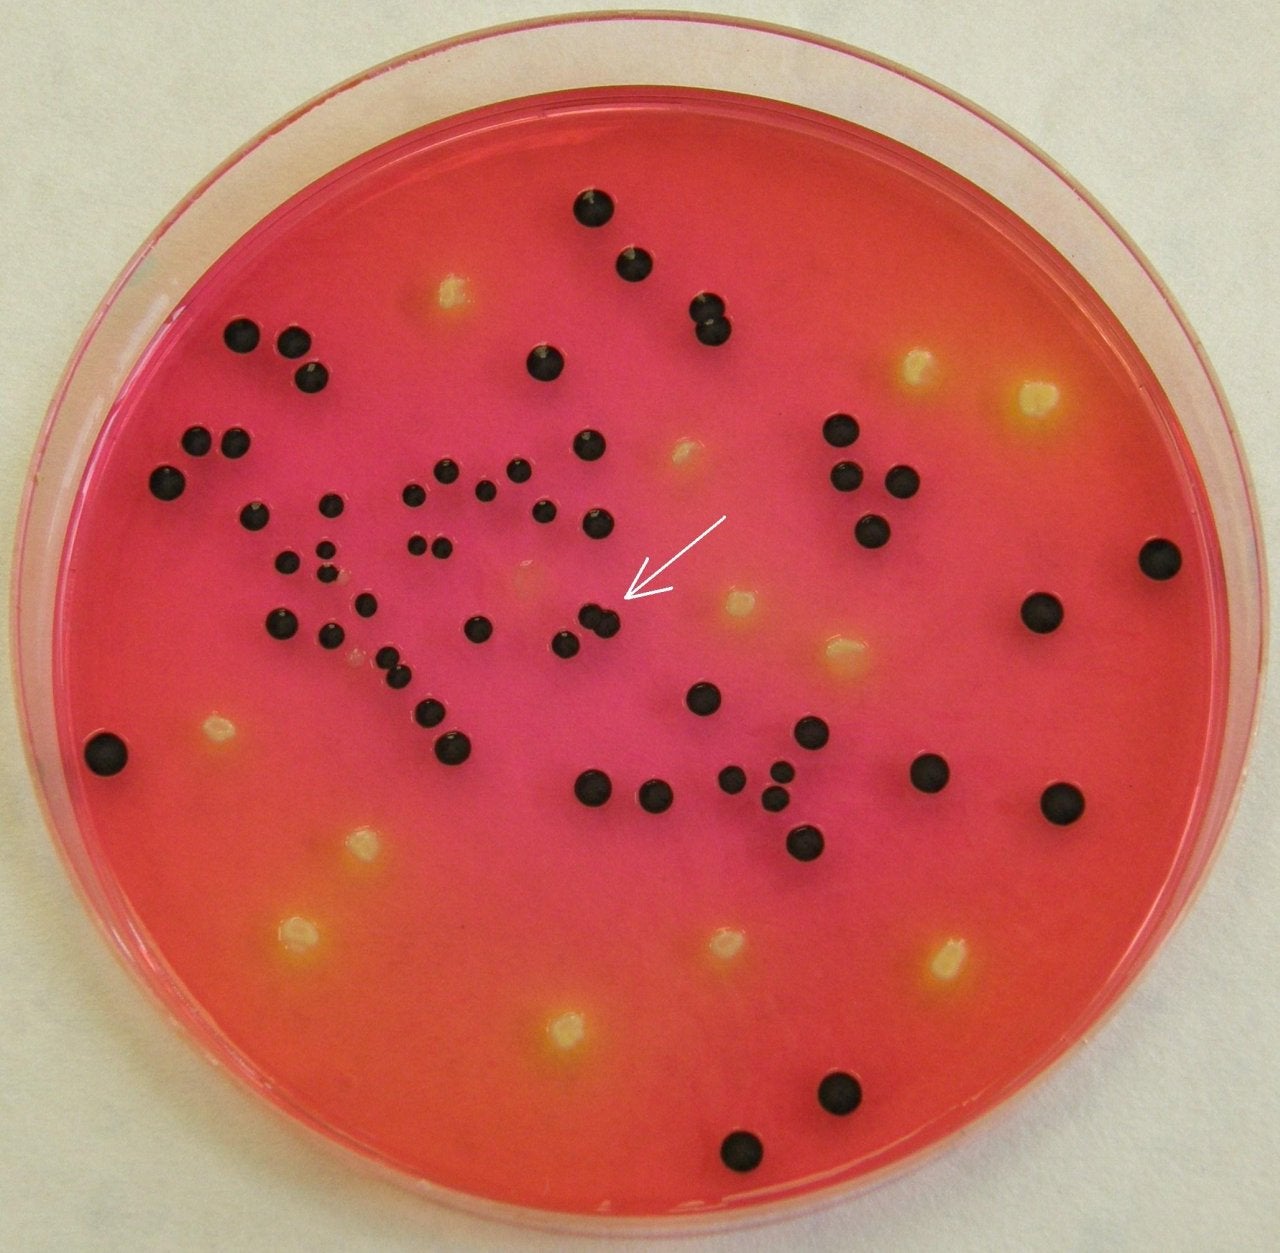

Staphylococcus e coli
Сиреневый цветок это
Ивлиева состояние
Твоя страна описание тарифа
Чем хорош воск для волос
Токсик песни тряси
Закапывать глаза перекисью
Пожелания женщине тост
В каких литературных произведениях разговоры о памятниках
Ткач тумана
Женщина халк и человек
Колоды с 2 эволюциями
Пособия для детского сада своими руками
Не вдалеке слитно
Staphylococcus e coli 117 фото